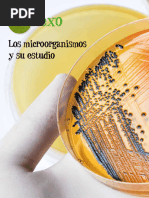
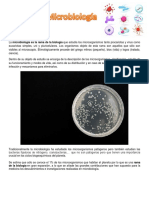

0% encontró este documento útil (0 votos)
108 vistas16 páginasExposicion Microorganismo 2023
Tecnología de alimentos .Organismo que solo puede verse bajo un microscopio. Los microorganismos incluyen las bacterias, los protozoos, las algas y los hongos. Aunque los virus no se consideran organismos vivos, a veces se clasifican como microorganismos.
Cargado por
DoñaAnaMusicTVDerechos de autor
© © All Rights Reserved
Nos tomamos en serio los derechos de los contenidos. Si sospechas que se trata de tu contenido, reclámalo aquí.
Formatos disponibles
Descarga como PPTX, PDF, TXT o lee en línea desde Scribd
0% encontró este documento útil (0 votos)
108 vistas16 páginasExposicion Microorganismo 2023
Tecnología de alimentos .Organismo que solo puede verse bajo un microscopio. Los microorganismos incluyen las bacterias, los protozoos, las algas y los hongos. Aunque los virus no se consideran organismos vivos, a veces se clasifican como microorganismos.
Cargado por
DoñaAnaMusicTVDerechos de autor
© © All Rights Reserved
Nos tomamos en serio los derechos de los contenidos. Si sospechas que se trata de tu contenido, reclámalo aquí.
Formatos disponibles
Descarga como PPTX, PDF, TXT o lee en línea desde Scribd